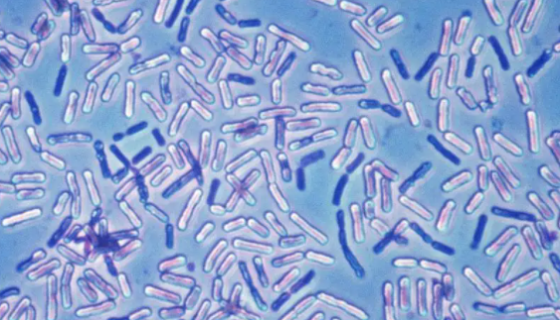
萎缩芽孢杆菌的形态特征与培养方法及操作流程！
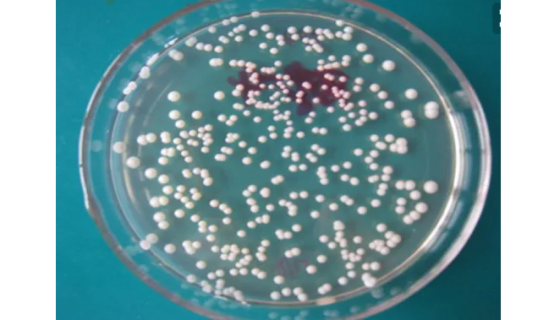
鲁氏酵母的主要用途及单层冻干管打管说明！
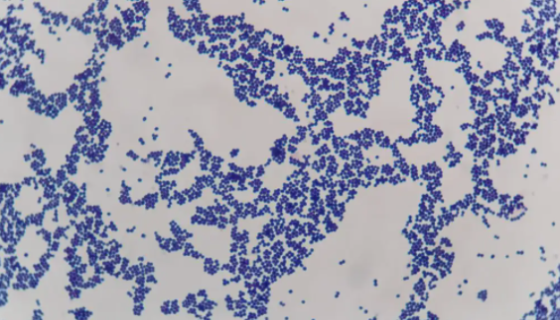
ATCC 49134 表皮葡萄球菌的菌株形态与注意事项！

粉红单端孢霉的菌株特点及培养与保存方法!
粉红单端孢霉是Trichothecium属的微生物,原产地为...

ATCC BAA-1706 肺炎克雷伯菌肺炎亚种知识解析!
肺炎克雷伯菌肺炎亚种是Klebsiella属的微生物,原产地...
萎缩芽孢杆菌的形态特征与培养方法及操作流程!
萎缩芽孢杆菌是Bacillus属的微生物,原产地为中国。好氧...

ATCC 30486 棘阿米巴原虫 百欧博伟生物
棘阿米巴原虫(Acanthamoeba))是一类自由生活的小...
鲁氏酵母的主要用途及单层冻干管打管说明!
鲁氏酵母是一种淀粉酶,活力较强,耐高渗透压,用于制酱油和甜酱...

CHO(仓鼠卵巢细胞)的复苏操作要点及注意事项!
仓鼠卵巢细胞是上皮细胞,贴壁生长,仅用于科学研究或者工业应用...

肠沙门氏菌肠亚种鼠伤寒血清型ATCC 13311的注意事项!
肠沙门氏菌肠亚种鼠伤寒血清型是Salmonella属的微生物...

ATCC 27048 深红红螺菌单层冻干管打管说明!
深红红螺菌,是红螺菌属内的一个模式种。有鞭毛运动、以二等分裂...
ATCC 49134 表皮葡萄球菌的菌株形态与注意事项!
表皮葡萄球菌(Staphylococcus epidermi...